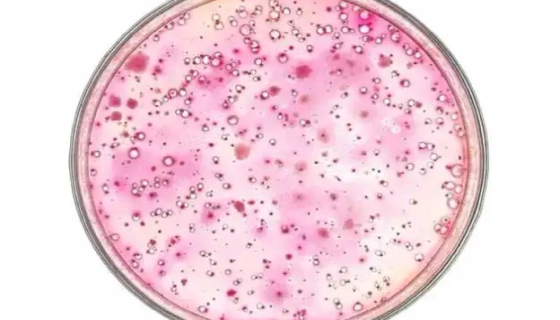
MUG培养基的背景与应用！百欧博伟生物
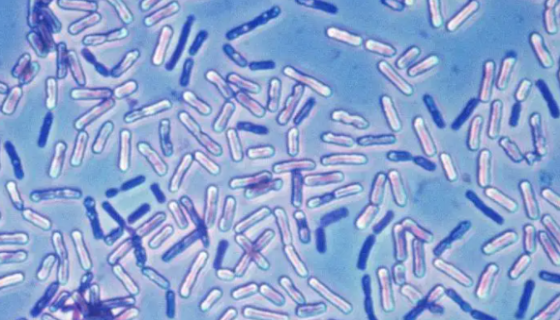
酪酸梭状芽孢杆菌的生物学特性与临床应用及作用机制！

洛氏普雷沃氏菌的概论及操作说明
普雷沃氏菌(Prevotella)是正常寄生于人体的条件致病...

嗜热毁丝菌的菌株特点与形态特征及主要价值!
嗜热毁丝菌是Myceliophthora属的微生物,原产地为...

淋病奈瑟氏球菌的知识简介及临床意义!
淋球菌是淋病奈瑟球菌的俗称,为严格的人体寄生菌,常存在于急性...
MUG培养基的背景与应用!百欧博伟生物
MUG培养基主要用于生活饮用水及其水源水中大肠菌群和大肠埃希...

人胰岛细胞的运输和保存及注意事项!
胰腺分为外分泌腺和内分泌腺两部分。外分泌腺由腺泡和腺管组成,...

枯草芽孢杆菌噬菌体的培养条件与注意事项!
枯草芽孢杆菌菌体生长过程中产生的枯草菌素、多粘菌素、制霉菌素...

副溶血性弧菌的发病机理与临床表现及预防与治疗!
副溶血性弧菌(Vibrio Parahemolyticus)...

人血管内皮细胞的生理功能及相关研究!
血管内皮细胞是血液与血管壁之间的屏障,内皮细胞具有细胞通透性...
酪酸梭状芽孢杆菌的生物学特性与临床应用及作用机制!
酪酸梭状芽孢杆菌为酪酸梭菌活菌(芽孢)制剂,能耐受胃酸进入肠...